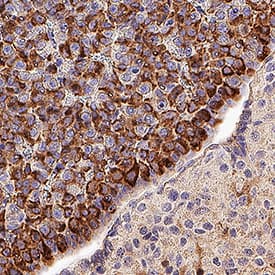

Mouse/Rat Prolactin Antibody
R&D Systems, part of Bio-Techne | Catalog # AF1445


Key Product Details
Species Reactivity
Validated:
Cited:
Applications
Validated:
Cited:
Label
Antibody Source
Product Specifications
Immunogen
Leu32-Cys228
Accession # NP_035294
Specificity
Clonality
Host
Isotype
Endotoxin Level
Scientific Data Images for Mouse/Rat Prolactin Antibody
Detection of Mouse and Rat Prolactin by Western Blot.
Western blot shows lysates of mouse pituitary tissue and rat pituitary tissue. PVDF membrane was probed with 0.25 µg/mL of Goat Anti-Mouse/Rat Prolactin Antigen Affinity-purified Polyclonal Antibody (Catalog # AF1445) followed by HRP-conjugated Anti-Goat IgG Secondary Antibody (HAF017). A specific band was detected for Prolactin at approximately 23 kDa (as indicated). This experiment was conducted under reducing conditions and using Immunoblot Buffer Group 1.Cell Proliferation Induced by Prolactin and Neutralization by Mouse Prolactin Antibody.
Recombinant Mouse Prolactin (1445-PL) stimulates proliferation in the Nb2-11 rat lymphoma cell line in a dose-dependent manner (orange line). Proliferation elicited by Recombinant Mouse Prolactin (10 ng/mL) is neutralized (green line) by increasing concentrations of Goat Anti-Mouse/Rat Prolactin Antigen Affinity-purified Polyclonal Antibody (Catalog # AF1445). The ND50 is typically 0.25-1.0 µg/mL.Detection of Prolactin in Mouse Pituitary.
Prolactin was detected in immersion fixed paraffin-embedded sections of Mouse Pituitary using Goat Anti-Mouse/Rat Prolactin Antigen Affinity-purified Polyclonal Antibody (Catalog # AF1445) at 1 µg/mL overnight at 4 °C. Tissue was stained using the Anti-Goat IgG VisUCyte™ HRP Polymer Antibody (brown; Catalog # VC004) and counterstained with hematoxylin (blue). Specific staining was localized to cytoplasm in lactotroph cells. View our protocol for IHC Staining with VisUCyte HRP Polymer Detection Reagents.Applications for Mouse/Rat Prolactin Antibody
Immunohistochemistry
Sample: Immersion fixed paraffin-embedded sections of Mouse Pituitary
Simple Western
Sample: Mouse pituitary tissue and rat pituitary tissue
Western Blot
Sample: Mouse pituitary tissue and rat pituitary tissue
Neutralization
Mouse Prolactin Sandwich Immunoassay
Formulation, Preparation, and Storage
Purification
Reconstitution
Formulation
*Small pack size (-SP) is supplied either lyophilized or as a 0.2 µm filtered solution in PBS.
Shipping
Stability & Storage
- 12 months from date of receipt, -20 to -70 °C as supplied.
- 1 month, 2 to 8 °C under sterile conditions after reconstitution.
- 6 months, -20 to -70 °C under sterile conditions after reconstitution.
Background: Prolactin
Prolactin (PRL) is a neuroendocrine pituitary hormone. Prolactin is synthesized by the anterior pituitary, placenta, brain, uterus, dermal fibroblasts, decidua, B cells, T cells, NK cells and breast cancer cells. Originally characterized as a lactogenic hormone, further studies have demonstrated broader roles in breast cancer development, regulation of reproductive function, and immunoregulation. In the immune system, Prolactin has been shown to be secreted by human PBMC and to act as a proliferative growth factor. Additionally, Prolactin treatment of human PBMC has been shown to enhance IFN-gamma production. In the breast, Prolactin-induced morphogenesis of the mammary cells is mediated through IGF-2, which in turn upregulates cyclin D1. Prolactin has several molecular forms. The predominant form is a monomer; the non-glycosylated form is 23 kDa and the glycosylated form is 25 kDa. Glycosylated Prolactin is removed from the circulation faster and has been reported to have lower biological potency. Mouse Prolactin cDNA encodes a 228 amino acid (aa) residue protein with a putative 31 aa residue signal peptide. The Prolactin receptor is a transmembrane type I glycoprotein that belongs to the cytokine hematopoietic receptor family. B cells, T cells, macrophages, NK cells, monocytes, CD34+ progenitor cells, neutrophils, mammary gland, liver, kidney, adrenals, ovaries, testis, prostrate, seminal vesicles, and hypothalamus have all been shown to express the Prolactin receptor. Three forms of the receptor, generated by differential splicing, have been identified. These isoforms differ in the length of their cytoplasmic domains. It is believed that the short cytoplasmic form is non-functional. Prolactin signal transduction involves the JAK/STAT families and Src kinase family (1‑9).
References
- Freeman, M. et al. (2000) Physiological Reviews 80:1523.
- Ben-Johnson, N. et al. (1996) Endoc. Rev. 17:639.
- Cesario, T. et al. (1994) Proc. Soc. Exp. Biol. Med. 205:89.
- Price, A.E. et al. (1995) Endoc. 136:4827.
- Hoffmann, T. et al. (1993) J. Endoc. Invest. 16:807.
- Cole, E. et al. (1991) Endoc. 129:2639.
- Lewis, U. et al. (1985) Endoc. 116:359.
- Matalk, K. (2003) Cytokine 21:187.
- Brisken, C. et al. (2002) Dev. Cell 3:877.
Alternate Names
Gene Symbol
UniProt
Additional Prolactin Products
Product Documents for Mouse/Rat Prolactin Antibody
Product Specific Notices for Mouse/Rat Prolactin Antibody
For research use only